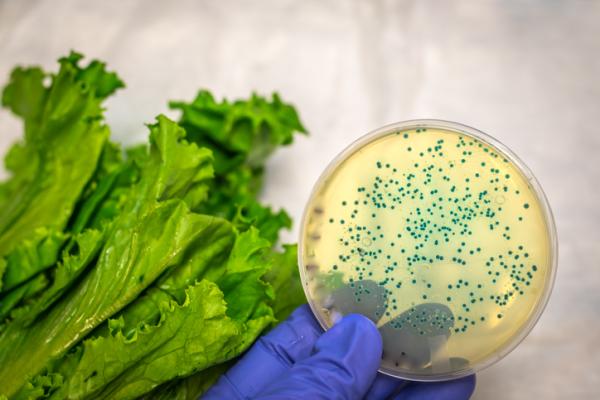
contaminacion_biologica_que_es_tipos_y_ejemplos_2517_600

Soluciones enzimáticas para una producción más eficiente
En Alimentos Biológicos BCN desarrollamos e implementamos soluciones enzimáticas personalizadas para los sectores de zumos, molinería, panadería y más. Nuestra experiencia y compromiso nos convierten en tu mejor aliado en Barcelona.
Innovación y rendimiento
Título de la sección secundaria de la página web
Analizamos tus procesos y diseñamos aplicaciones enzimáticas específicas que mejoran la calidad, el rendimiento y la sostenibilidad de tu producción. Con nosotros, obtienes soluciones efectivas y ajustadas a tu industria.